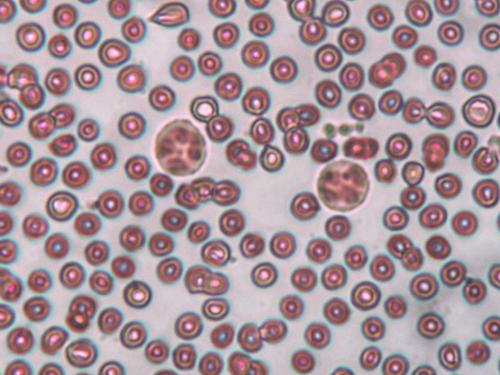
细胞染色缓冲液

细胞染色缓冲液
询价
500 ml
起订
北京 更新日期:2026-04-05
产品详情:
- 中文名称:
- 细胞染色缓冲液
- 产品类别:
- 流式辅助试剂
公司简介
北京博蕾德生物科技有限公司是一家专注于生命科学和生物技术领域,我们始终拥有的创业激情,自成立以来,每年销售保持高速增长,企业规模不断扩大,并且与国际众多著名品牌我们签约,
Abbexa,American Diagnostica Inc,Alpha Diagnostic International,Bachem,BTI,BioMaTIK,CALBIOTECH,
Chondrex,DIACLONE,GREER,Hypoxyprobe,Kamiya,List Biological,Life Diagnostics INC,Moleoular Innovations,
MatTek,Mybiosource,NoVaTec,Prospec,QuickZyme,Southernbiotech等20余欧美著名生物技术公司产品代理产品涉及,分子生化试剂、免疫试剂和细胞培养试剂等,已被广泛应用于生命科学基础研究、开发应用、制药、人口与健康、生物技术等诸多领域。客
| 成立日期 | (20年) |
| 注册资本 | 200.000000万人民币 |
| 员工人数 | 50-100人 |
| 年营业额 | ¥ 300万-500万 |
| 经营模式 | 贸易,工厂,试剂,定制 |
| 主营行业 | 生化试剂,抗体,蛋白组学,分子生物学,细胞生物学 |
细胞染色缓冲液相关厂家报价
-

- Elabscience 细胞染色缓冲液-E-CK-A107
- 武汉伊莱瑞特生物科技股份有限公司 VIP
- 2026-03-26
- ¥900
-

- 10倍浓缩细胞裂解缓冲液
- 上海优宁维生物科技股份有限公司 VIP
- 2026-04-10
- 询价
-

- TBS缓冲液Tris缓冲盐溶液
- 武汉卡诺斯科技有限公司 VIP
- 2026-04-10
- 询价
-

- 氨氯化铵缓冲液;氨氯化铵缓冲液甲
- 天津市恒兴化学试剂制造有限公司 VIP
- 2026-04-10
- 询价